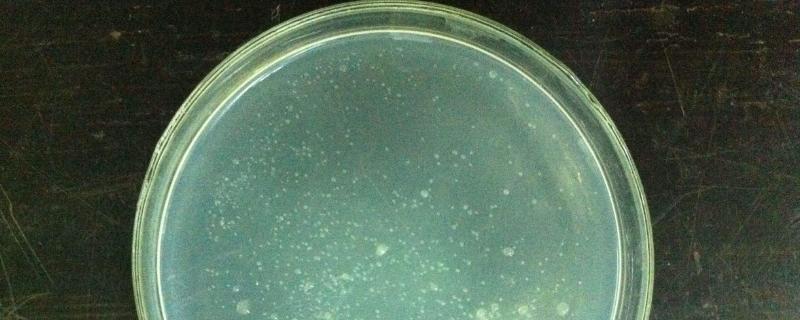
酵母菌的繁殖方式，是真菌还是细菌

在鸡舍里点蚊香对鸡有影响吗,鸡舍如何消毒

在鸡舍里点蚊香对鸡没有影响。夏天蚊子太多的话一定要把鸡舍搞干净,让它干燥,不要让它潮湿,然后就可以点蚊香。鸡也怕蚊子叮咬,鸡虽然身上有毛,但是蚊子也会叮咬,而且还会传播疾病,感染鸡痘。夏季高温的时候,根据温度的上升情况,将养殖密度适量减少,一般在夏季,每平方米饲养4-5只鸡是最好的。
一、在鸡舍里点蚊香对鸡有影响吗
1、在鸡舍里点蚊香对鸡没有影响。如果夏天蚊子太多,首先一定要把鸡舍卫生搞干净,而且要让鸡舍干燥,不能让它潮湿,然后就可以点蚊香。注意,由于鸡舍里面是通风的,所以在点蚊香时一定不能碰到易燃物品,注意安全。
2、鸡非常怕蚊子叮咬,虽然它身上的羽毛比较浓密但蚊子也会叮咬到。蚊子会传播疾病,使其感染鸡痘,影响身体健康。所以为了避免鸡被蚊子叮咬,一定要做好防蚊措施,使用蚊香驱蚊是目前最方便的方法。也可以在鸡笼外面蒙上蚊帐,这样也能使其避免蚊子叮咬。
3、在夏季高温时,一定要根据温度上升情况,将养殖密度进行减少,一般在夏季,每平方米养殖4-5只鸡即可,随着温度的变化可以进行适当调整。从鸡舍的内外环境饮水、饲料、鸡群到工作人员的正常出入和操作规程都必须要有明确的消毒规定,这样才能保证鸡群的健康,杜绝各种传染病发生。
二、鸡舍如何消毒
1、带鸡消毒
(1)带鸡消毒是鸡舍消毒方法中比较常见的一种,要注意观察鸡舍中鸡的生长状况,选择对鸡无刺激或者是刺激性比较小的消毒剂。
(2)消毒时可以使用喷雾喷洒的方法,全面均匀的喷洒在鸡舍里面,这是一种减少灰尘,预防鸡呼吸道疾病的消毒方法。
(3)带鸡消毒不仅可以消灭存在于鸡舍空气里面的有害物质,而且还能够提高空气质量。
(4)带鸡消毒还是一种控制鸡舍温湿度的方法,但是它对预防肠胃道疾病没有很大的效果。
2、饮水消毒
(1)饮水是病菌感染鸡体的主要途径之一,不管是什么样的饮水方式,如果没有做好饮水消毒工作,病菌都可以过水进行繁殖污染。
(2)鸡饮用后会感染肠胃道,导致产生肠胃道疾病。
(3)饮水消毒可以将饮水中的病菌杀死,防止病菌寄生在水中进入鸡的身体,发生肠胃道疾病。
(4)可以在水中添加适量的消毒剂,这样不仅对鸡没有太大影响,而且还有利于促进鸡的生长,提高鸡的成活率与饲料转化率,降低发病率。
3、紫外线消毒
(1)紫外线消毒是一种比较少见的方法,但是它的效果非常明显。
(2)紫外线消毒可以改变微生物的细胞结构,杀死病菌或者降低活力,并且还能改变病菌的基因,使其对鸡失去威胁。
(3)但是由于紫外线对人体的危害比较大,所以在使用时一定要慎重。
(4)消毒时尽量不要进入鸡舍,将鸡与紫外灯要保持1米左右的距离,消毒时间不能低于20分钟,否则效果不明显。
4、熏蒸消毒
(1)熏蒸消毒就是将消毒剂蒸发然后散播在空气中“对抗”病菌,熏蒸消毒可以减少甚至消灭病菌。
(2)熏蒸消毒比较适合在空舍时使用,通常在肉鸡出栏后,对鸡舍及饲养设备消毒时就可以使用熏蒸消毒的方法。
(3)熏蒸消毒的主要材料就是甲醛,甲醛能够抑制一些病菌传播,但它也会对鸡甚至是人造成危害,所以一般适用于空舍消毒。